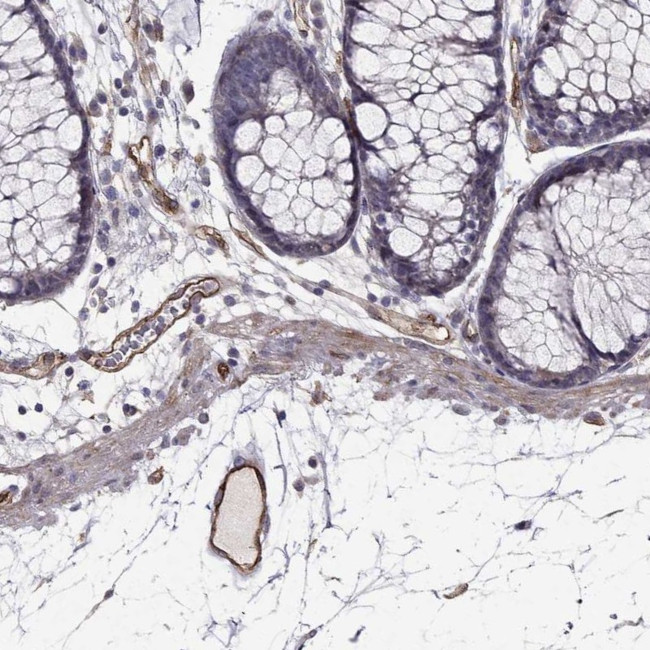
RASIP1 Antibody in Immunohistochemistry (Paraffin) (IHC (P))

Search
Invitrogen
RASIP1 Polyclonal Antibody
{{$productOrderCtrl.translations['antibody.pdp.commerceCard.promotion.promotions']}}
{{$productOrderCtrl.translations['antibody.pdp.commerceCard.promotion.viewpromo']}}
{{$productOrderCtrl.translations['antibody.pdp.commerceCard.promotion.promocode']}}: {{promo.promoCode}} {{promo.promoTitle}} {{promo.promoDescription}}. {{$productOrderCtrl.translations['antibody.pdp.commerceCard.promotion.learnmore']}}
产品信息
PA5-85026
种属反应
宿主/亚型
分类
类型
抗原
偶联物
形式
浓度
规格
纯化类型
保存液
内含物
保存条件
运输条件
RRID
产品详细信息
Immunogen sequence: CNDLELCDEA MALLDEVIMC TFQQSVYYLT KTLYSTLPAL LDSNPFTAGA ELPGPGAELG AMPPGLRP
Highest antigen sequence indentity to the following orthologs: Mouse - 97%, Rat - 97%.
靶标信息
Required for the proper formation of vascular structures that develop via both vasculogenesis and angiogenesis. Acts as a critical and vascular-specific regulator of GTPase signaling, cell architecture, and adhesion, which is essential for endothelial cell morphogenesis and blood vessel tubulogenesis. Regulates the activity of Rho GTPases in part by recruiting ARHGAP29 and suppressing RhoA signaling and dampening ROCK and MYH9 activities in endothelial cells. May act as effector for Golgi-bound HRAS and other Ras-like proteins. May promote HRAS-mediated transformation. Negative regulator of amino acid starvation-induced autophagy.
仅用于科研。不用于诊断过程。未经明确授权不得转售。
篇参考文献 (0)
生物信息学
蛋白别名: RAIN; Ras-interacting protein 1; unnamed protein product
基因别名: RAIN; RASIP1
UniProt ID: (Human) Q5U651
Entrez Gene ID: (Human) 54922